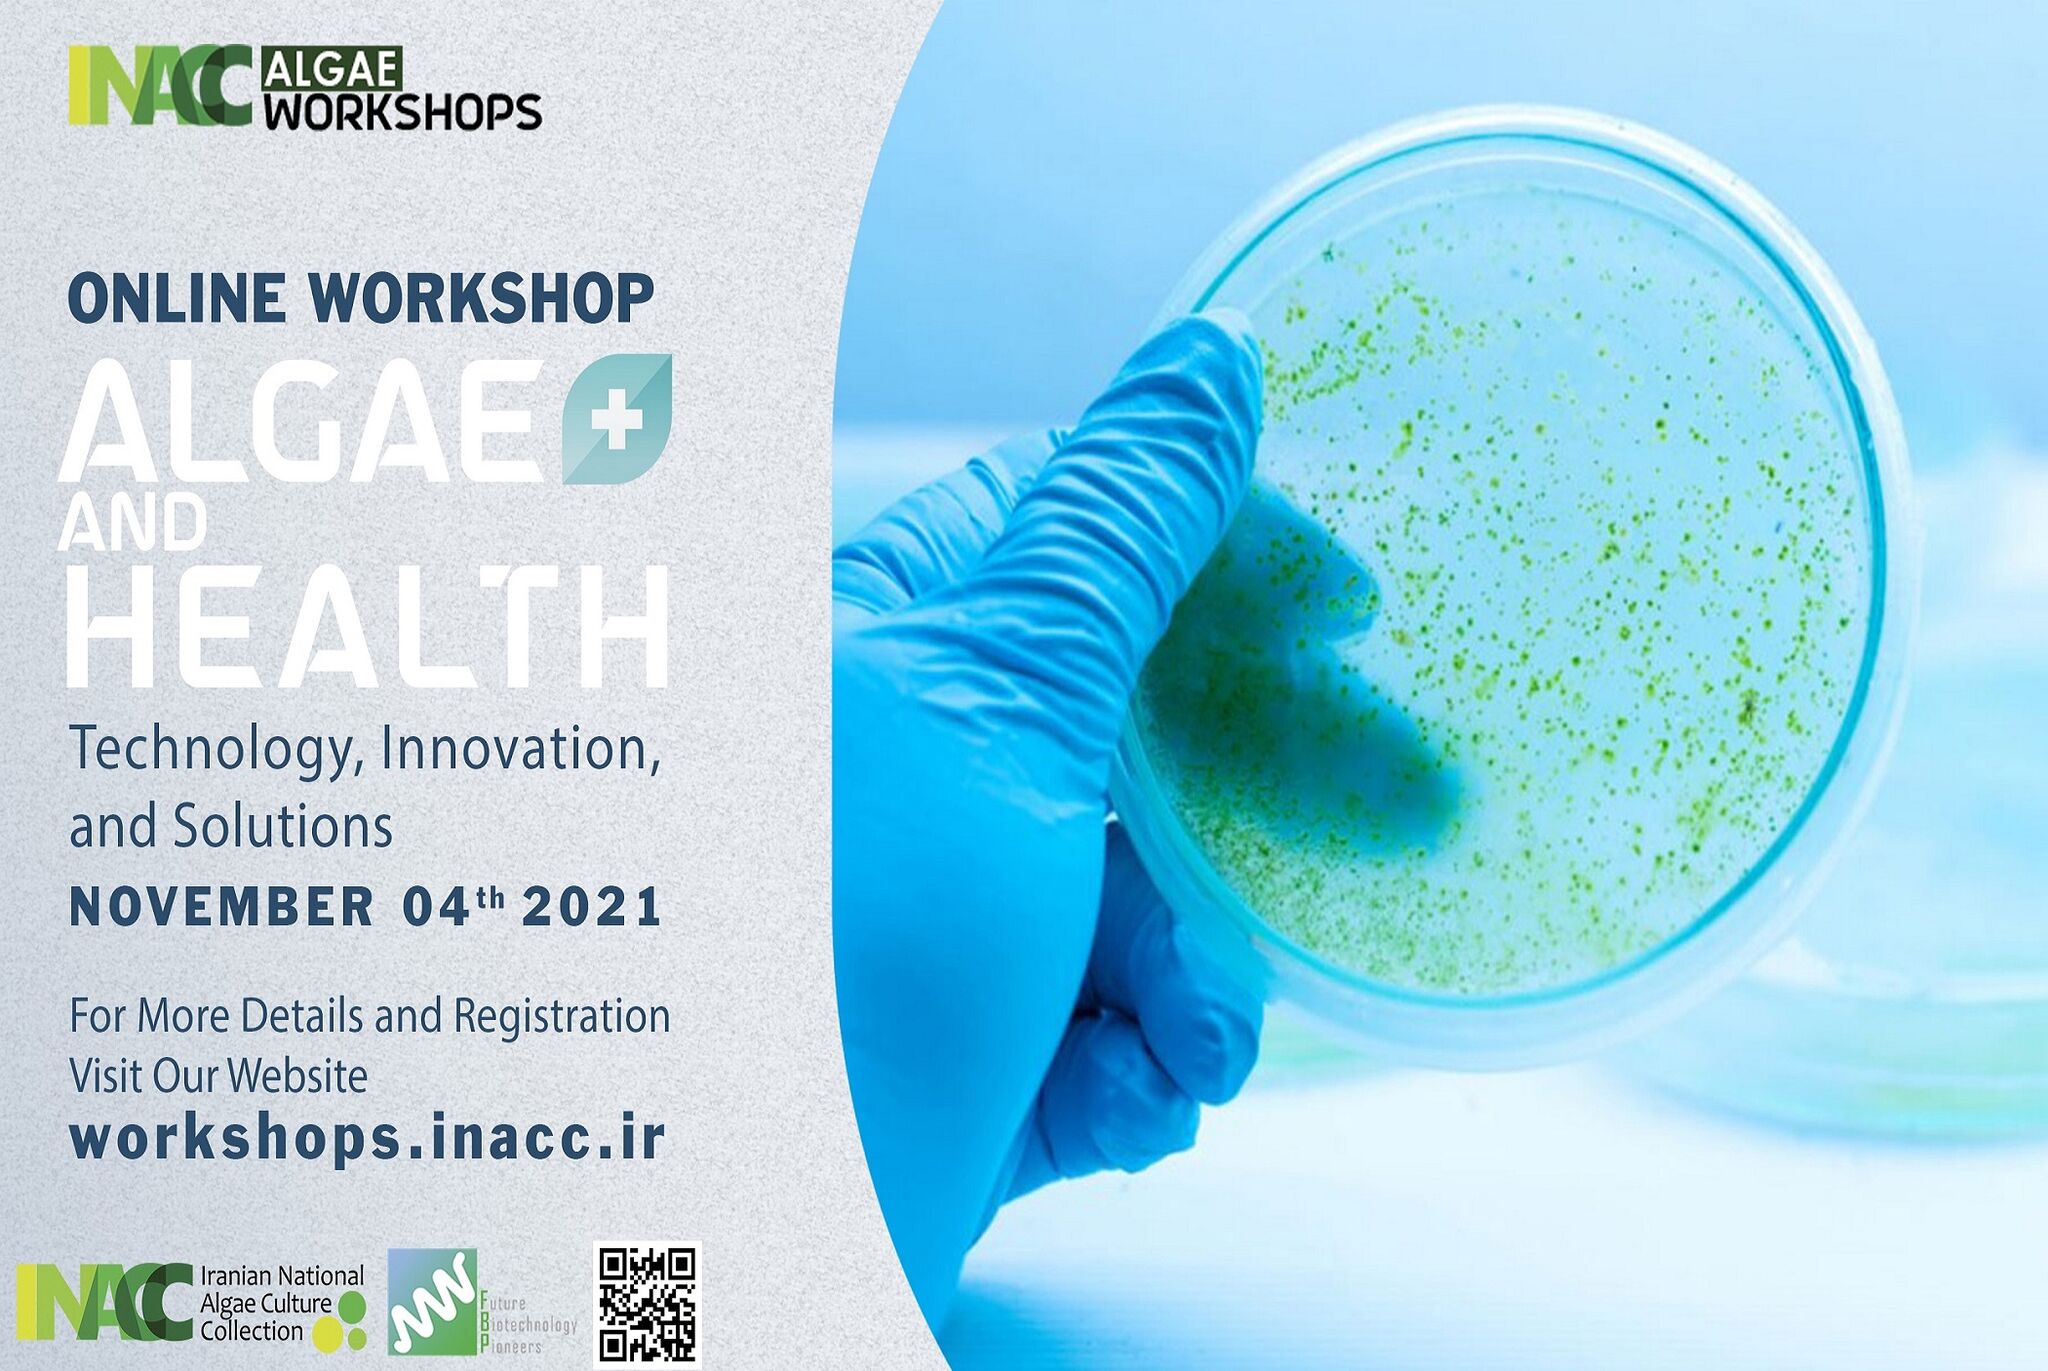
Image

IRAN ALAGE 2025
About the Workshop
Hosted by the Iran National Algae Culture Collection (INACC), the IRANALGAE workshop leverages years of specialized experience in promoting global collaboration and knowledge exchange. Since its inception, this series has served as a vital bridge between scientific discovery and practical application.
Our Values
Humanity & Algae Thriving Toghether
Networking Opportunities
Interactive Workshops
About Us
Hosted by the Iran National Algae Culture Collection (INACC), the IRANALGAE workshop leverages years of specialized experience in promoting global collaboration and knowledge exchange. Since its inception, this series has served as a vital bridge between scientific discovery and practical application. Over the past four editions—ranging from our 2021 debut to the 2024 "Algae Leave No One Behind!" session—IRANALGAE has successfully brought together a diverse community of biologists, phycologists, environmental scientists, and researchers from across the globe.
As we mark the 5th edition of IRANALGAE in 2025, under the theme “Symbiotic Future: Humanity and Algae Thriving Together,” the workshop enters a new phase of evolution. While this edition was initially designed as a hybrid event, the 5th IRANALGAE Workshop will be held in an offline format to ensure continuity, focus, and high-quality scientific exchange. The workshop remains firmly committed to its core mission: fostering international collaboration, highlighting cutting-edge developments in algal research, and exploring the role of algae in building a resilient and symbiotic future for humanity and the planet. To extend the reach of the workshop beyond the physical venue, all invited presentations will be made available through INACC’s official platforms, ensuring broad access to the scientific contributions shared during the event.
Innovation
What to Expect at IRANALGAE 2025
Guided by the theme “Symbiotic Future: Humanity and Algae Thriving Together,” IRANALGAE 2025 brings together diverse perspectives that examine how algae and human systems can co‑evolve across science, technology, industry, and society.
IRANALGAE 2025 offers participants access to a curated collection of expert-led presentations covering a broad spectrum of contemporary algal science and applications. Registered participants will have on-demand access to all recorded talks, allowing them to explore the content at their own pace and according to their interests. The workshop content spans fundamental research, applied technologies, circular bioeconomy solutions, and societal integration of algae.
Highlights
Pervious IRAN ALAGE Workshops